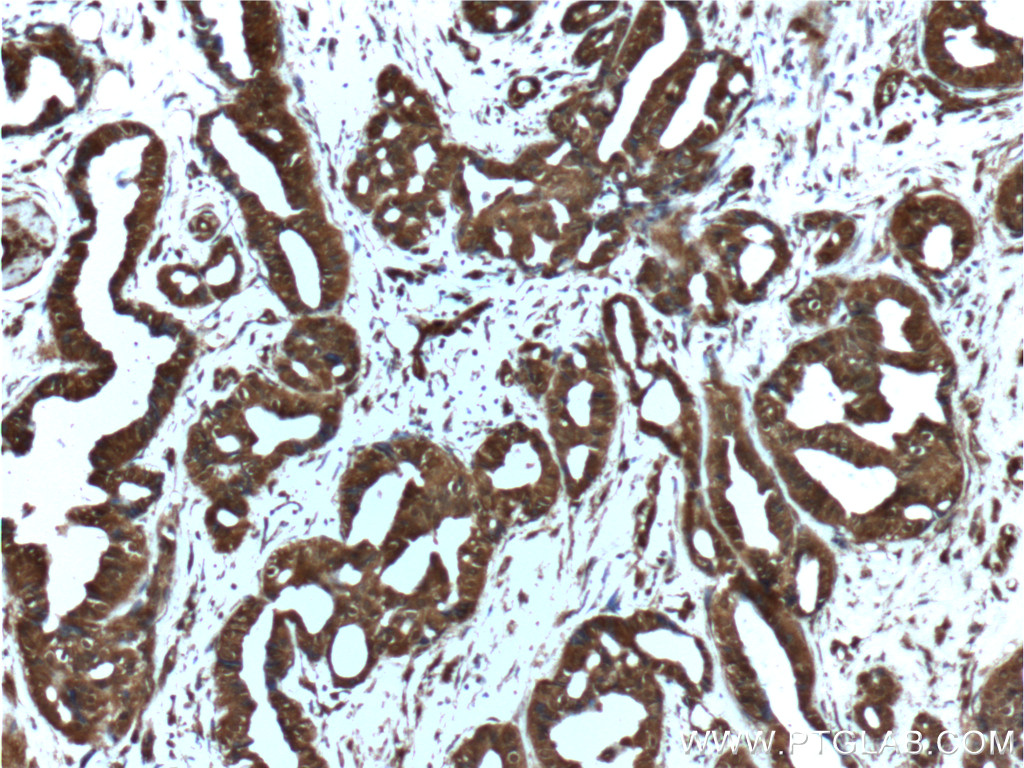

验证数据展示
经过测试的应用
| Positive WB detected in | HeLa cells, A549 cells |
| Positive IHC detected in | human breast cancer tissue, human prostate cancer tissue Note: suggested antigen retrieval with TE buffer pH 9.0; (*) Alternatively, antigen retrieval may be performed with citrate buffer pH 6.0 |
推荐稀释比
| 应用 | 推荐稀释比 |
|---|---|
| Western Blot (WB) | WB : 1:500-1:1000 |
| Immunohistochemistry (IHC) | IHC : 1:50-1:500 |
| It is recommended that this reagent should be titrated in each testing system to obtain optimal results. | |
| Sample-dependent, Check data in validation data gallery. | |
发表文章中的应用
| WB | See 6 publications below |
| IHC | See 1 publications below |
产品信息
55230-1-AP targets AKT in WB, IHC, ELISA applications and shows reactivity with human, Mouse samples.
| 经测试应用 | WB, IHC, ELISA Application Description |
| 文献引用应用 | WB, IHC |
| 经测试反应性 | human, Mouse |
| 文献引用反应性 | human, mouse, rat |
| 免疫原 |
Peptide 种属同源性预测 |
| 宿主/亚型 | Rabbit / IgG |
| 抗体类别 | Polyclonal |
| 产品类型 | Antibody |
| 全称 | v-akt murine thymoma viral oncogene homolog 1 |
| 别名 | AKT, AKT1, PKB, PKB ALPHA, PRKBA, Protein kinase B, Proto oncogene c Akt, RAC, RAC ALPHA, RAC PK alpha |
| 计算分子量 | 56 kDa |
| 观测分子量 | 56-62 kDa |
| GenBank蛋白编号 | NM_001014431 |
| 基因名称 | AKT1 |
| Gene ID (NCBI) | 207 |
| RRID | AB_2881292 |
| 偶联类型 | Unconjugated |
| 形式 | Liquid |
| 纯化方式 | Antigen affinity purification |
| UNIPROT ID | P31749 |
| 储存缓冲液 | PBS with 0.02% sodium azide and 50% glycerol, pH 7.3. |
| 储存条件 | Store at -20°C. Aliquoting is unnecessary for -20oC storage. |
背景介绍
AKT1, also named as PKB and RAC, belongs to the protein kinase superfamily, AGC Ser/Thr protein kinase family and RAC subfamily. It plays a role as a key modulator of the AKT-mTOR signaling pathway controlling the tempo of the process of newborn neurons integration during adult neurogenesis, including correct neuron positioning, dendritic development and synapse formation. AKT1 promotes glycogen synthesis by mediating the insulin-induced activation of glycogen synthase. It plays a role in glucose transport by mediating insulin-induced translocation of the GLUT4 glucose transporter to the cell surface. AKT1 mediates the antiapoptotic effects of IGF-I. (PMID:16139227)This antibody is specific to AKT1. It has no cross reaction to AKT2 and AKT3.
发表文章
| Species | Application | Title |
|---|---|---|
Mol Med Rep Matrine inhibits the invasive and migratory properties of human hepatocellular carcinoma by regulating epithelial‑mesenchymal transition. | ||
J Immunol The Intracellular Interaction of Porcine β-Defensin 2 with VASH1 Alleviates Inflammation via Akt Signaling Pathway. | ||
Int J Mol Sci Extracellular Calcium-Induced Calcium Transient Regulating the Proliferation of Osteoblasts through Glycolysis Metabolism Pathways | ||
J Ethnopharmacol Shenqu xiaoshi oral solution enhances digestive function and stabilizes the gastrointestinal microbiota of juvenile rats with infantile anorexia | ||
Acta Biochim Biophys Sin (Shanghai) Multiple circRNAs regulated by QKI5 conjointly spongemiR-214-3p to antagonize bisphenol A-inducedspermatocyte toxicity |